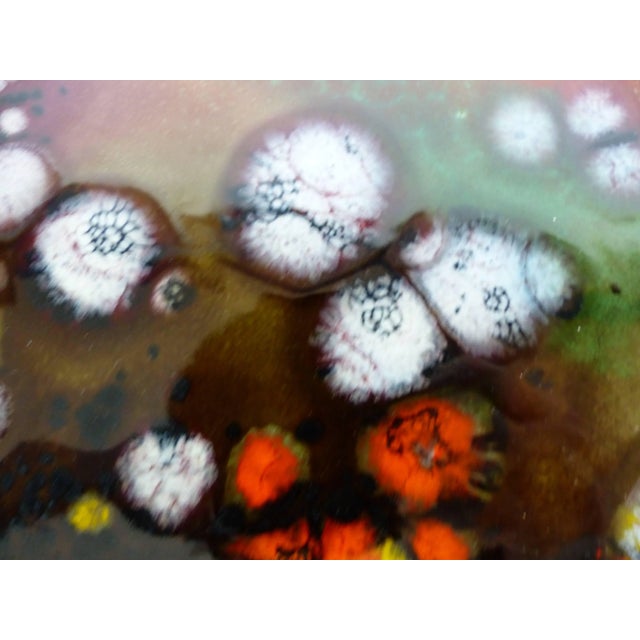
Juan Navarrete Ceramic Hanging Charger Offered is a large and brightly colored ceramic wall hanging charger titled Volcano...
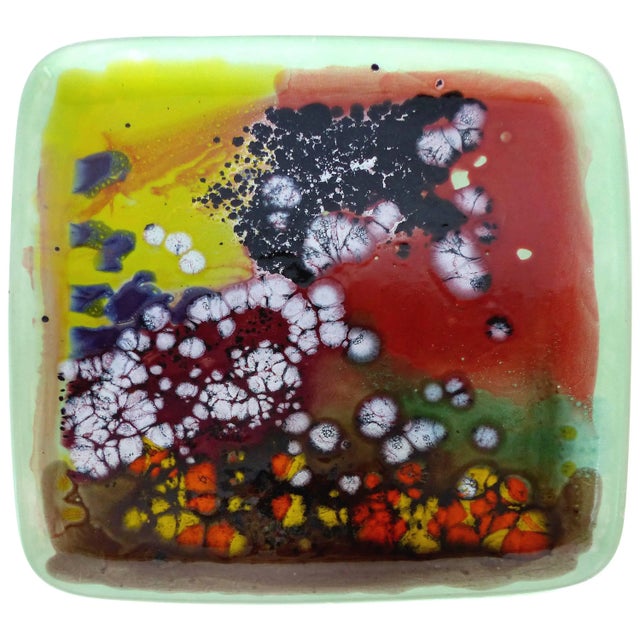
Juan Navarrete Ceramic Hanging Charger For Sale - Image 11 of 11

Details
Description
Juan Navarrete Ceramic Hanging Charger
Offered is a large and brightly colored ceramic wall hanging charger titled Volcano Green by …
Read more
Juan Navarrete Ceramic Hanging Charger
Offered is a large and brightly colored ceramic wall hanging charger titled Volcano Green by Juan A.Navarrette. Navarrete was born in Havana, Cuba, in 1952. A versatile artist, he is an accomplished painter, draftsman, and ceramist. Signed, titled and dated 2012 on the base. Hanging wire provided.
See less
- Dimensions
- 14.5ʺW × 14.5ʺD × 1.12ʺH
- Styles
- Contemporary
- Period
- Early 21st Century
- Item Type
- Vintage, Antique or Pre-owned
- Materials
- Ceramic
- Condition
- Good Condition, Original Condition Unaltered, Some Imperfections
- Color
- Condition Notes
- Excellent Excellent less
Questions about the item?
Returns & Cancellations
Return Policy - All sales are final 48 hours after delivery, unless otherwise specified in the description of the product.
Related Collections
- Pink Fenton Art Glass Company Vases
- Loetz Vases
- Gae Aulenti Vases
- Pottery Barn Vases
- Red Fenton Art Glass Company Vases
- Mazzega Murano Vases
- Toso Murano Vases
- Pickard China Vases
- Bristol Porcelain Vases
- Lapis Lazuli Vases
- Ikea Vases
- Shannon Crystal Vases
- Licio Zanetti Vases
- Carlsbad Porcelain Vases
- Luciano Gaspari Vases
- Roycroft Vases
- Westmorland Vases
- Schneider Glass Vases
- Axel Salto Vases
- Ridgway Porcelain Vases
- Ward Bennett Vases
- Boda Nova Glassworks Vases
- Arzbeg Porcelain Vases
- Lyngby Porcelain Vases
- Union Porcelain Works Vases